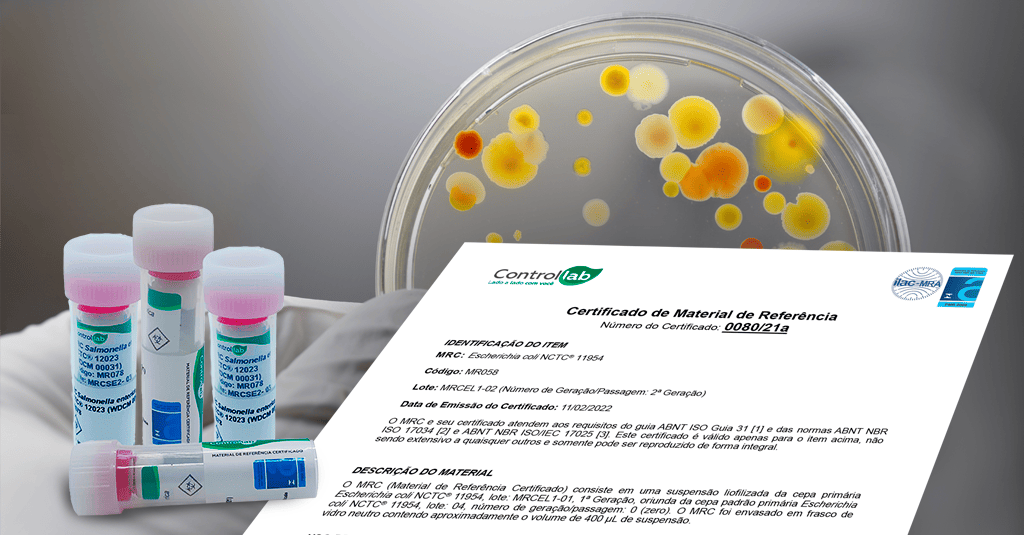

A credibilidade das coleções de cultura com o reconhecimento de Material de Referência Certificado (MRC).
Na rotina dos laboratórios de análises, as cepas de referência são fundamentais para o controle da qualidade dos insumos utilizados nos exames de diagnóstico clínico, veterinário, nas análises microbiológicas de alimentos, água, produtos farmacêuticos e meio ambiente. Elas também são indispensáveis para estudos de validação de métodos e determinação da incerteza de medição.
Nos processos analíticos, o Material de Referência Certificado (MRC) é a recomendação prioritária da ABNT NBR ISO/IEC 17025 e da ABNT NBR ISO 15189 para rastreabilidade metrológica. Esses MRCs são produzidos em conformidade com critérios aceitos internacionalmente e estabelecidos na ABNT NBR ISO 17034.
Já pensou em ter na sua rotina cepas de referência reconhecidas como Materiais de Referência Certificados?
Essa união representa o patamar máximo de qualidade e rastreabilidade metrológica, respaldado pelas principais normas e referências internacionais. Um diferencial que consolida o compromisso do seu laboratório com a exatidão e a confiança nos resultados microbiológicos.
Para tornar esse padrão de qualidade acessível aos laboratórios, a Controllab disponibiliza cepas de referência reconhecidas como Materiais de Referência Certificados.
A empresa é acreditada como Produtora de Material de Referência (PMR 0009) pela Coordenação Geral de Acreditação do Inmetro e licenciada pela Agência de Segurança Sanitária do Reino Unido (UK HSA) para as coleções de cultura NCTC® (National Collection of Type Cultures) — a coleção de bactérias mais antiga do mundo — e NCPF® (National Collection of Pathogenic Fungi).
Equivalência das principais coleções de cultura
A NCTC®, assim como a ATCC®, é uma referência mundial para coleções de culturas. Ambas são registradas no WDCM (World Data Center for Microorganisms), um banco de dados internacional que agrupa cepas em um sistema único de identificadores. Isso facilita a comparação e o compartilhamento de informações sobre cepas de referência.
No WDCM, uma mesma cepa pode ter diferentes designações conforme a coleção. Por exemplo, a Escherichia coli NCTC® 12241 é também designada ATCC® 25922, CIP® 76.24, DSM® 1103, CCUG® 17620, CECT® 434, dependendo da coleção de cultura.
Portanto, ao usar uma cepa NCTC® ou uma ATCC®, você está utilizando cepas equivalentes, com as mesmas características fenotípicas e genotípicas. Os protocolos técnicos e os órgãos acreditadores reconhecem essa equivalência, assegurando a conformidade entre as coleções.
Por que escolher as Cepas de Referência Controllab?
Ao adotar as Cepas de Referência Controllab, o laboratório traz para sua rotina o rigor da ISO 17034 aliado à confiabilidade das coleções de cultura reconhecidas internacionalmente.
Por que escolher as Cepas de Referência Controllab?
Ao adotar as Cepas de Referência Controllab, o laboratório traz para sua rotina o rigor da ISO 17034 aliado à confiabilidade das coleções de cultura reconhecidas internacionalmente.
Com o programa Cepas Controle, o laboratório passa a contar com cepas programadas que simplificam processos complexos, reduzem riscos de contaminação e mutações, eliminam a necessidade de manutenção interna e liberam tempo para o que realmente importa: resultados precisos e confiáveis.
Mais do que uma escolha técnica, é uma decisão que reflete o compromisso do laboratório com a excelência e a segurança em cada resultado entregue.
Quer assegurar a qualidade analítica e fortalecer a confiança dos seus resultados?
Fale com um especialista da Controllab.




